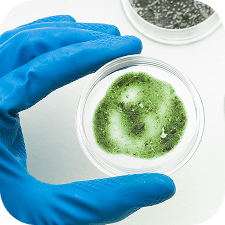

Buy 2 Get 1 FREE
& Fast Shipping From USA














Harness the power of medical-grade UV-C technology—the same used in hospitals and airlines—to eradicate mold, bacteria, and germs by destroying their DNA to stop them from spreading.
Prevent expensive mold damage and shocking medical bills with medical-grade UV-C technology, safe and easy for anyone to use at home.
With up to 200 square feet of cleaning power, you can sanitize small rooms in just 15 to 60 minutes, all WITHOUT:

Mold in your home is a serious (and expensive) problem.
By the time you can see mold in your bathroom, it has already been growing and spreading for up to 3 weeks, penetrating the walls and potentially causing long-term damage.
Best of all, you’ll enjoy a fresh, clean scent without having to scrub the walls or spray toxic aerosols ever again!


with significant reductions observed under controlled conditions. Effective doses were achieved with UV intensities cycling over time, offering promising applications for indoor mold control.”
Published in PLOS ONE
Intermittent Low-Dose Far-UVC Irradiation Inhibits Growth of Common Mold Below Threshold Limit Value, 2023.
Protecting your family killing germs and removing allergens you can’t even see!
Even if your home doesn’t look dusty and dirty, it could have billions of microscopic germs, bacteria, viruses, and allergens, putting your and your family at risk…
Not to mention dust mites leaving eggs and feces in your bed.
The Swissklip HaloUV is the easiest way to eliminate harmful invaders and get long-lasting relief from allergies all year long.
Click below to save 50% and try it out for yourself risk free for 30 days:
Fresh Home, Healthier Family & Protected Surfaces – Or Your Money Back


We’re confident you’ll love the product but if you’re not satisfied with the results, simply inform us within 30 days of purchase for a full refund.
Just contact our amazing customer support team via e-mail at support@swissklip.com and ask for a full refund.


Plug the device in. Make sure there are no pets, plants, or children in the area.


Use the remote control and set the timer by choosing your desired setting. Leave the room and close the door.


After the timer is up, the device will automatically turn off. Come back in 15 to 60 minutes and enjoy fresh, purified air!






Wow!!!!
Setting it up was a breeze – literally just plug it in, set the timer, and let it do its thing. I was a little nervous at first, especially about the whole UV light thing, but the instructions were clear about keeping the room empty and safe. The first time I used it in the bedroom, I set it for 30 minutes, and when I walked back in, I swear the air felt different. It’s hard to describe, but it was like the room had been aired out, but better. The musty smell that always lingered was completely gone.




Simple, effective, and just what I needed. Overall, I’m really impressed with the Swissklip HaloUV. It’s definitely made my home feel fresher and cleaner in a way that scrubbing and vacuuming alone never could




I was initially skeptical about the effectiveness of the HaloUV, but after using it for a few weeks, I’m blown away by the results. Not only does it sanitize my home effectively, but it also eliminates lingering odors and leaves the air feeling fresh. As a busy mom, having a convenient and reliable way to keep my home clean and healthy is invaluable. I highly recommend the HaloUV to anyone looking for a hassle-free solution to improve indoor air quality.




I’ve tried everything to get rid of that stale smell in my apartment. This UV sanitizer did the trick in just a few days!




After a week of using it in different rooms, I noticed a significant difference in my allergies. Usually, I wake up with a stuffy nose and itchy eyes, but that’s almost completely gone now. I’ve also been sleeping better – less tossing and turning, and I wake up feeling more rested. I didn’t expect a gadget to make such a big difference, but here we are.




After a week of using it in different rooms, I noticed a significant difference in my allergies. Usually, I wake up with a stuffy nose and itchy eyes, but that’s almost completely gone now. I’ve also been sleeping better – less tossing and turning, and I wake up feeling more rested. I didn’t expect a gadget to make such a big difference, but here we are.




I’ve tried just about everything to keep my apartment free of allergens and that weird, stale smell that seems to build up no matter how much I clean. My partner and I both have allergies, so we’re constantly battling sneezing fits, especially in the mornings. We’ve tried air purifiers, essential oils, deep cleaning – you name it, nothing compares to this one, I noticed a big difference in just a few days. The air is so much fresher, and I’m breathing easier… it def destroys all the dust mites.




I’ve tried just about everything to keep my apartment free of allergens and that weird, stale smell that seems to build up no matter how much I clean. My partner and I both have allergies, so we’re constantly battling sneezing fits, especially in the mornings. We’ve tried air purifiers, essential oils, deep cleaning – you name it, nothing compares to this one, I noticed a big difference in just a few days. The air is so much fresher, and I’m breathing easier… it def destroys all the dust mites.




Excellent! The room smells cleaner and the dust is almost nonexistent now. Super happy with this purchase.




Didn’t think it would actually make a difference but wow, you can feel the air is cleaner, even my headaches are less frequent.
Absolutely. With an intuitive remote control and a simple timer function, the HaloUV is designed for ease of use, ensuring a hassle-free sanitization experience for everyone.
Sanitization times can vary from 15 to 60 minutes depending on room size. Regular use, especially in high-traffic areas or during allergy seasons, is recommended to maintain a clean and healthy environment.


Hair Removal Devices





